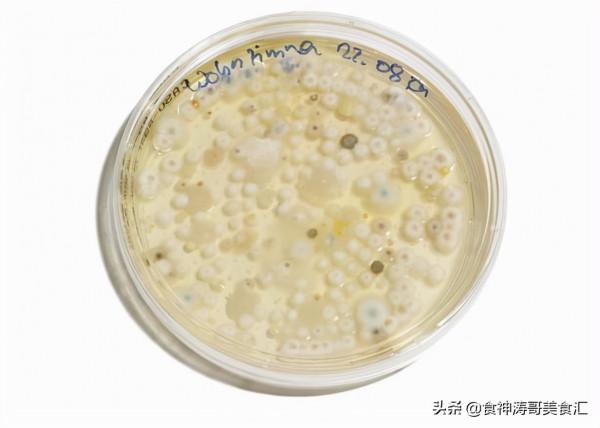
都說東北是美食的“荒漠”,那是不瞭解黑龍江,看看當地10大美食 都說東北是美食的“荒漠”,那是不瞭解黑龍江,看看當地10大美食

黑龍江省位於我國東北的北部,面積約47萬平方公里,這裡土地肥沃,水資源豐富,盛產山蔬,野味、肉禽和淡水魚蝦,是我國著名的北大倉。據說以前黑龍江這條江叫白龍江,說是裡面有條白龍,時常興風作浪。一個山東人來到白龍江打敗了禍害百姓的白龍,從此生活在白龍江,老百姓感他,所以把白龍江改名黑龍江。下面就來看看黑龍江10大美食。
1、酸湯子
酸湯子是東北地區特有的一種食物,用玉米發酵後製作而成,因口感爽滑、味道獨特,湯子味香而微酸,吃起來很開胃口。如果配上開春鮮嫩的韭菜炸的一碗雞蛋醬味道更加鮮美,所以深受當地人們的喜歡。但是可別小看這種美食,當地就有吃酸湯子導致中毒而亡的。
導致人們中毒的原因就是米酵菌酸,這是發酵後玉米黃桿菌分泌出的毒素。雖然黃桿菌產生的米酵菌酸是劇毒,可是黃桿菌本身卻是無毒的。食用酸湯子中毒原因是酸湯子儲存不當導致的。比如上次黑龍江食用酸湯子事件,米酵菌酸是不怕開水煮的。其分解溫度更是達到了大約280攝氏度,開水煮一煮也沒用。看到這裡外地食客你敢吃這種美食嗎?
所以家裡的食物發黴了,就一定不要食用了,即使家裡老人不願意扔掉,為了健康,我們最好想辦法說服他們,即使在冰箱儲存的食物也不要過久,細菌低溫下雖然繁殖慢,但不會停止繁殖。
2、東北大醬
在過去的時候,黑龍江幾乎家家戶戶都自己做大醬,每家院子裡都會有一個醬缸。那時候人們回家第一件事是拿醬杵子搗醬缸,防止大醬凝固成塊。吃飯的時候,會去醬缸裡盛幾勺大醬出來,蘸水蘿蔔、黃瓜、小蔥。還有種吃法,是用大葉生菜包米飯和菜,再抹上大醬,做成飯包。各家各戶做的大醬,味道千差萬別,有的槓香,有的微微發甜,有的純鹹。要是誰家出了一缸好醬,得到了誇獎,那就會用小罐頭瓶子分裝好,左鄰右舍挨家挨戶送。
黑龍江人從小到大吃到大的醬一共有三種,許氏大醬——這個很多人都說好吃,但是我很難接受它獨特的臭味。寶泉嶺——這個還不錯,中規中矩,呼瑪豆瓣醬——這個特別好吃。還有香其醬——一種味道調和過的熬製熟醬,也非常的美味。但是好多南方食客第一次聞到東北大醬都是說是有一股臭味。
3、蘸醬菜
為什麼黑龍江人人喜歡吃蘸醬菜?父母老家都是東北的,我小時候也問過這個問題。我大爺的解釋:“生吃多鮮靈啊。”我老姑的解釋:“省事兒。”我大姑父的解釋:“不搶灶眼,鍋裡燉著肉呢。”我媽的解釋:“吃這個好,敗火,助消化。”我爸的解釋:“東北這邊冬天冷,土壤裡寄生蟲啥的能凍死,吃生的沒事,你到南邊不能這麼吃。”我爺的解釋:“光吃雞蛋醬不鹹啊?”南方食客:沒有熱菜嗎?
過去黑龍江生活不好,冬天缺少蔬菜,夏天缺少肉食,不管啥菜,只要配上大醬,就能下飯,就能填飽肚子。現在的生活好了,不用再吃鹹的東西來省錢下飯了,每餐都會有各種時令蔬菜,但是東北人還是忘不了蘸醬菜這種搭配的味道。頂花帶刺的小黃瓜、嬌嫩的小水蘿蔔,白白淨淨的小香蔥,帶著水珠兒的生菜葉等等,蘸上大醬,咬一口就能回魂。
4、山野菜
知道每年開春的時候,從山上採下來的野菜,啥味道不?你知道那玩意兒多少錢一斤不?黑龍江一年四季分明,有近一半的時間是嚴冬酷雪,萬物凋敝,好不容易開春了,見綠了,正是吃山野菜的時候。婆婆丁、柳蒿芽、猴腿、刺老芽、銀耳、野蕨菜等,每種食材都有各種的吃法。吃不了的還可以曬乾儲存冬天吃,也可以凍上儲存。估計外地食客看著各種的野菜也是無從下嘴吧。
5、凍梨、凍柿子
說起這凍梨、凍柿子,黑龍江人可是再熟悉不過的。在以前,這可是當地人冬天裡最主要的水果了。自打進了臘月門兒,市場上就可見到這凍梨、凍柿子了。用涼水浸透了的凍梨, 在梨的外邊形成了一個堅硬的冰殼;去掉冰殼,便是這化得軟軟的凍梨了。吃時可直接咬著吃;也可先在凍梨的邊上咬上個小口兒,慢慢地吸吮裡邊的梨汁,涼涼的,甜甜的,那味道美著呢。
6、生魚片
黑龍江撫遠因魚而著名,只因身邊有著名的烏蘇里江。因此當地人有愛吃生魚片的習慣。人的味覺其實只有五種,酸甜苦鹹鮮,生魚片應該能體驗到鮮味和甜味,各種生魚的味道的理解都基於這個概念,有的脆爽,有的豐腴,有的香氣濃郁,有的氣味清淡,在保證食材新鮮,品質穩定的前提下,多做嘗試,總會遇到自己鍾愛的一款。不同生魚片有不同的味道,哪怕是魚的不同部位,味道也不一樣。白肉魚類味道相對淡一些,紅肉的濃烈一些。但也有外地食客評價味道又腥又冷,脂肪肥厚的魚肉腥味更加嗆人,入嘴的瞬間就融化脂肪化作血水,散發著魚肉特有的腥味。
7、酸菜
作為一個純正血統的東北人,酸菜是我絕對不能吃的東西(實在受不了那個味道)但是,酸菜對我來說意味著我每年冬天捏著鼻子走過的樓道(鄰居的酸菜缸放在樓道),意味著過年家裡一道固定的菜餚,意味著奶奶每年都要送來我家的吃食,意味著爸爸最喜歡的味道。酸菜對於老東北人來說,意味著冬天來了。酸菜餡餃子對於老東北人來說,意味著過年。
60、70後以及更早的老東北人的整個冬天,主菜就是這道酸菜。這應該意味著上一代東北人利用智慧與大自然鬥爭下產生的結晶,也是那個民以食為天的時代下老一輩東北人半輩子的情懷。
8、殺豬菜
我心中的殺豬菜一定是在各個車站附近的,小小的鋪面,門口用鐵皮桶支起的一口大鍋,老湯,豬骨,血腸,豬肝,酸菜一起咕嘟咕嘟冒泡沸騰著,在寒冷的冬季,無論多匆忙的腳步,都被他吸引去了,老闆會盛滿滿一碗帶著連湯帶菜,就著老闆給的一碟蒜泥,兩萬大米飯不是問題,還可以加錢讓老闆給切進血腸放進拆骨肉,怎一個香字了得。現在很多大點的東北菜館進門口也會砌上幾口大灶,總是會有這樣一鍋殺豬菜。正所謂喜歡吃的就愛這口,也有好多外地食客吃不了血腸和豬肝的味道。
9、格瓦斯
前幾年我回哈爾濱時,基本上到處都能買到格瓦斯這種飲料,小麥釀的,但是又不含酒精,味道是不苦還帶濃香甜味的飲料,個人覺得非常好喝。格瓦斯口味獨特,但就是因為太獨特,導致很多人都不喜歡喝,就變成了地域性或者區域性飲品,畢竟全國鋪貨的話,範圍大,成本也高。
10、老頭魚
老頭魚是黑龍江原本比較常見的一種野生魚,個頭很小我見過最大的也就巴掌大,肉食性情兇猛,喜歡吃小魚小蝦和同類,頭部很大但是傳說有寄生蟲沒有人吃。將老頭魚去頭後收拾乾淨,把鍋燒熱放入薑絲、蔥段、辣椒乾煸,然後放入東北大醬炒出香味,再放水燒開放入老頭魚小火慢燉。做好之後的老頭魚香甜可口、肉質軟嫩、刺少味鮮、回味無窮。現在野生的老頭魚越來越少,這魚也不太好養同類相吃得太厲害,再加上頭大不能吃,現在越來越貴了,我已經很久都沒有吃到過它們了,甚是懷念。
結束語
好多人說黑龍江是美食的荒漠,其實黑龍江有很多的美食,只不過是飲食習慣的不同。鶴崗小串、雞西冷麵、佳木斯拌麵、哈爾濱紅腸和烤冷麵、牡丹江開江魚、肇東烤餅、齊齊哈爾手拉麵、加格達奇烤肉、七臺河奶皮子等地,黑龍江太大了,好吃的也太多了,寫是寫不完了,朋友,只是希望看完這篇文章的你能重新認識一下黑龍江。
今天的分享就到這裡了,你最喜歡吃哪種美食小吃呢?歡迎在評論區留言,喜歡的朋友記得關注下,祝大家在2021年裡身體健康,財源滾滾,再見!